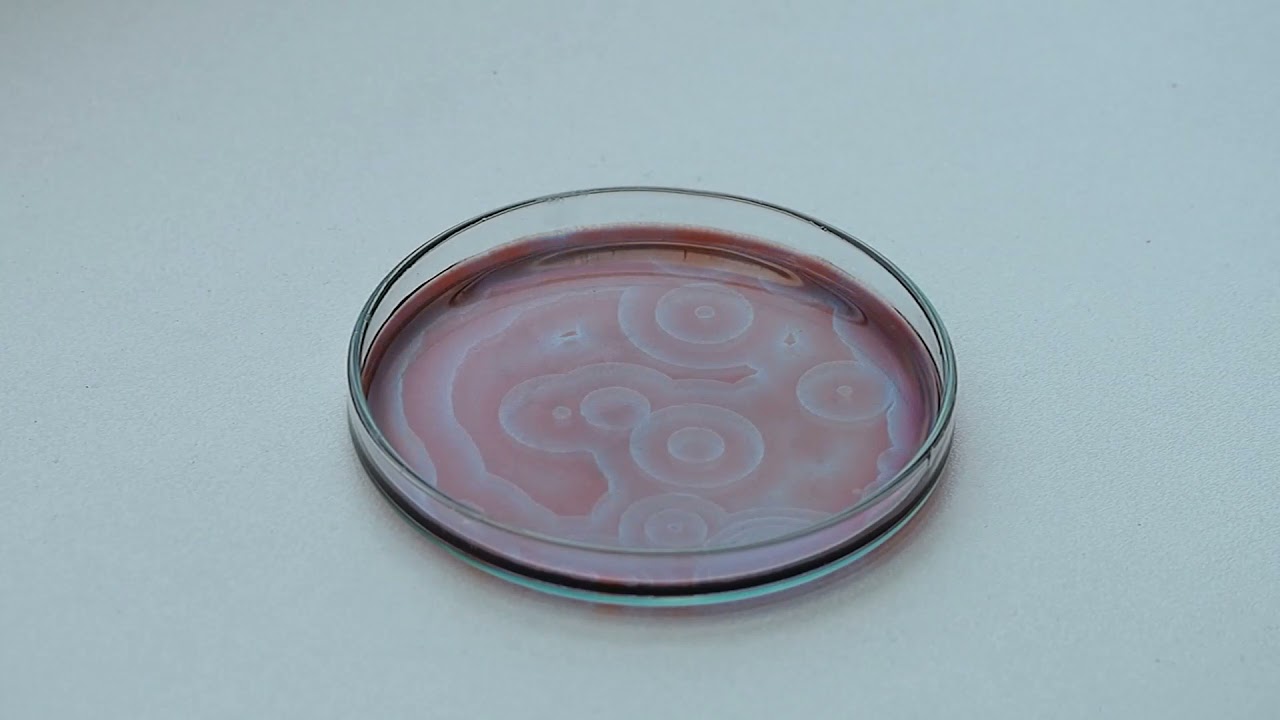
Belousov-Zhabotinsky reaktsioon

Последние добавленные видео:
reaktsioon
-
 11 месяцев назад
1113 11 месяцев назад 7:48
11 месяцев назад
1113 11 месяцев назад 7:48Keemiline reaktsioon. Tunnused | VIDEOÕPS Loodusõpetus #10
-
 16 лет назад
2207 16 лет назад 4:08
16 лет назад
2207 16 лет назад 4:08Reaktsioon: Benseen + Bromometaan
-
 11 лет назад
2540 11 лет назад 2:52
11 лет назад
2540 11 лет назад 2:52Metaani reaktsioon klooriga
-
 5 лет назад
546 5 лет назад 5:28
5 лет назад
546 5 лет назад 5:28The Free Musketeers - Reaktsioon
-
 4 года назад
626 4 года назад 20:08
4 года назад
626 4 года назад 20:08Molaarmass arvutusülesanne keemiline reaktsioon I
-
4 года назад
125 4 года назад 2:57
4 года назад
125 4 года назад 2:57Belousov-Zhabotinsky reaktsioon
-
 11 лет назад
990 11 лет назад 1:03
11 лет назад
990 11 лет назад 1:03Benseeni reaktsioon kloorioga
-
 2 недели назад
43 2 недели назад 2:43
2 недели назад
43 2 недели назад 2:43Dune Part Three First trailer reaktsioon
-
 12 лет назад
168 12 лет назад 1:25
12 лет назад
168 12 лет назад 1:25Lenne reaktsioon
-
 11 лет назад
310 11 лет назад 1:14
11 лет назад
310 11 лет назад 1:14Alkeeni reaktsioon halogeenvesinikuga
-
 7 лет назад
22 7 лет назад 1:26
7 лет назад
22 7 лет назад 1:26Reaktsioon: eksamisessioon
-
 6 лет назад
70 6 лет назад 8:16
6 лет назад
70 6 лет назад 8:16Sireti reaktsioon
-
 8 дней назад
13 8 дней назад 5:56
8 дней назад
13 8 дней назад 5:56Mis on mulla reaktsioon ja happesus?
-
 10 месяцев назад
47 10 месяцев назад 9:29
10 месяцев назад
47 10 месяцев назад 9:29Metalli reaktsioon happe või veega